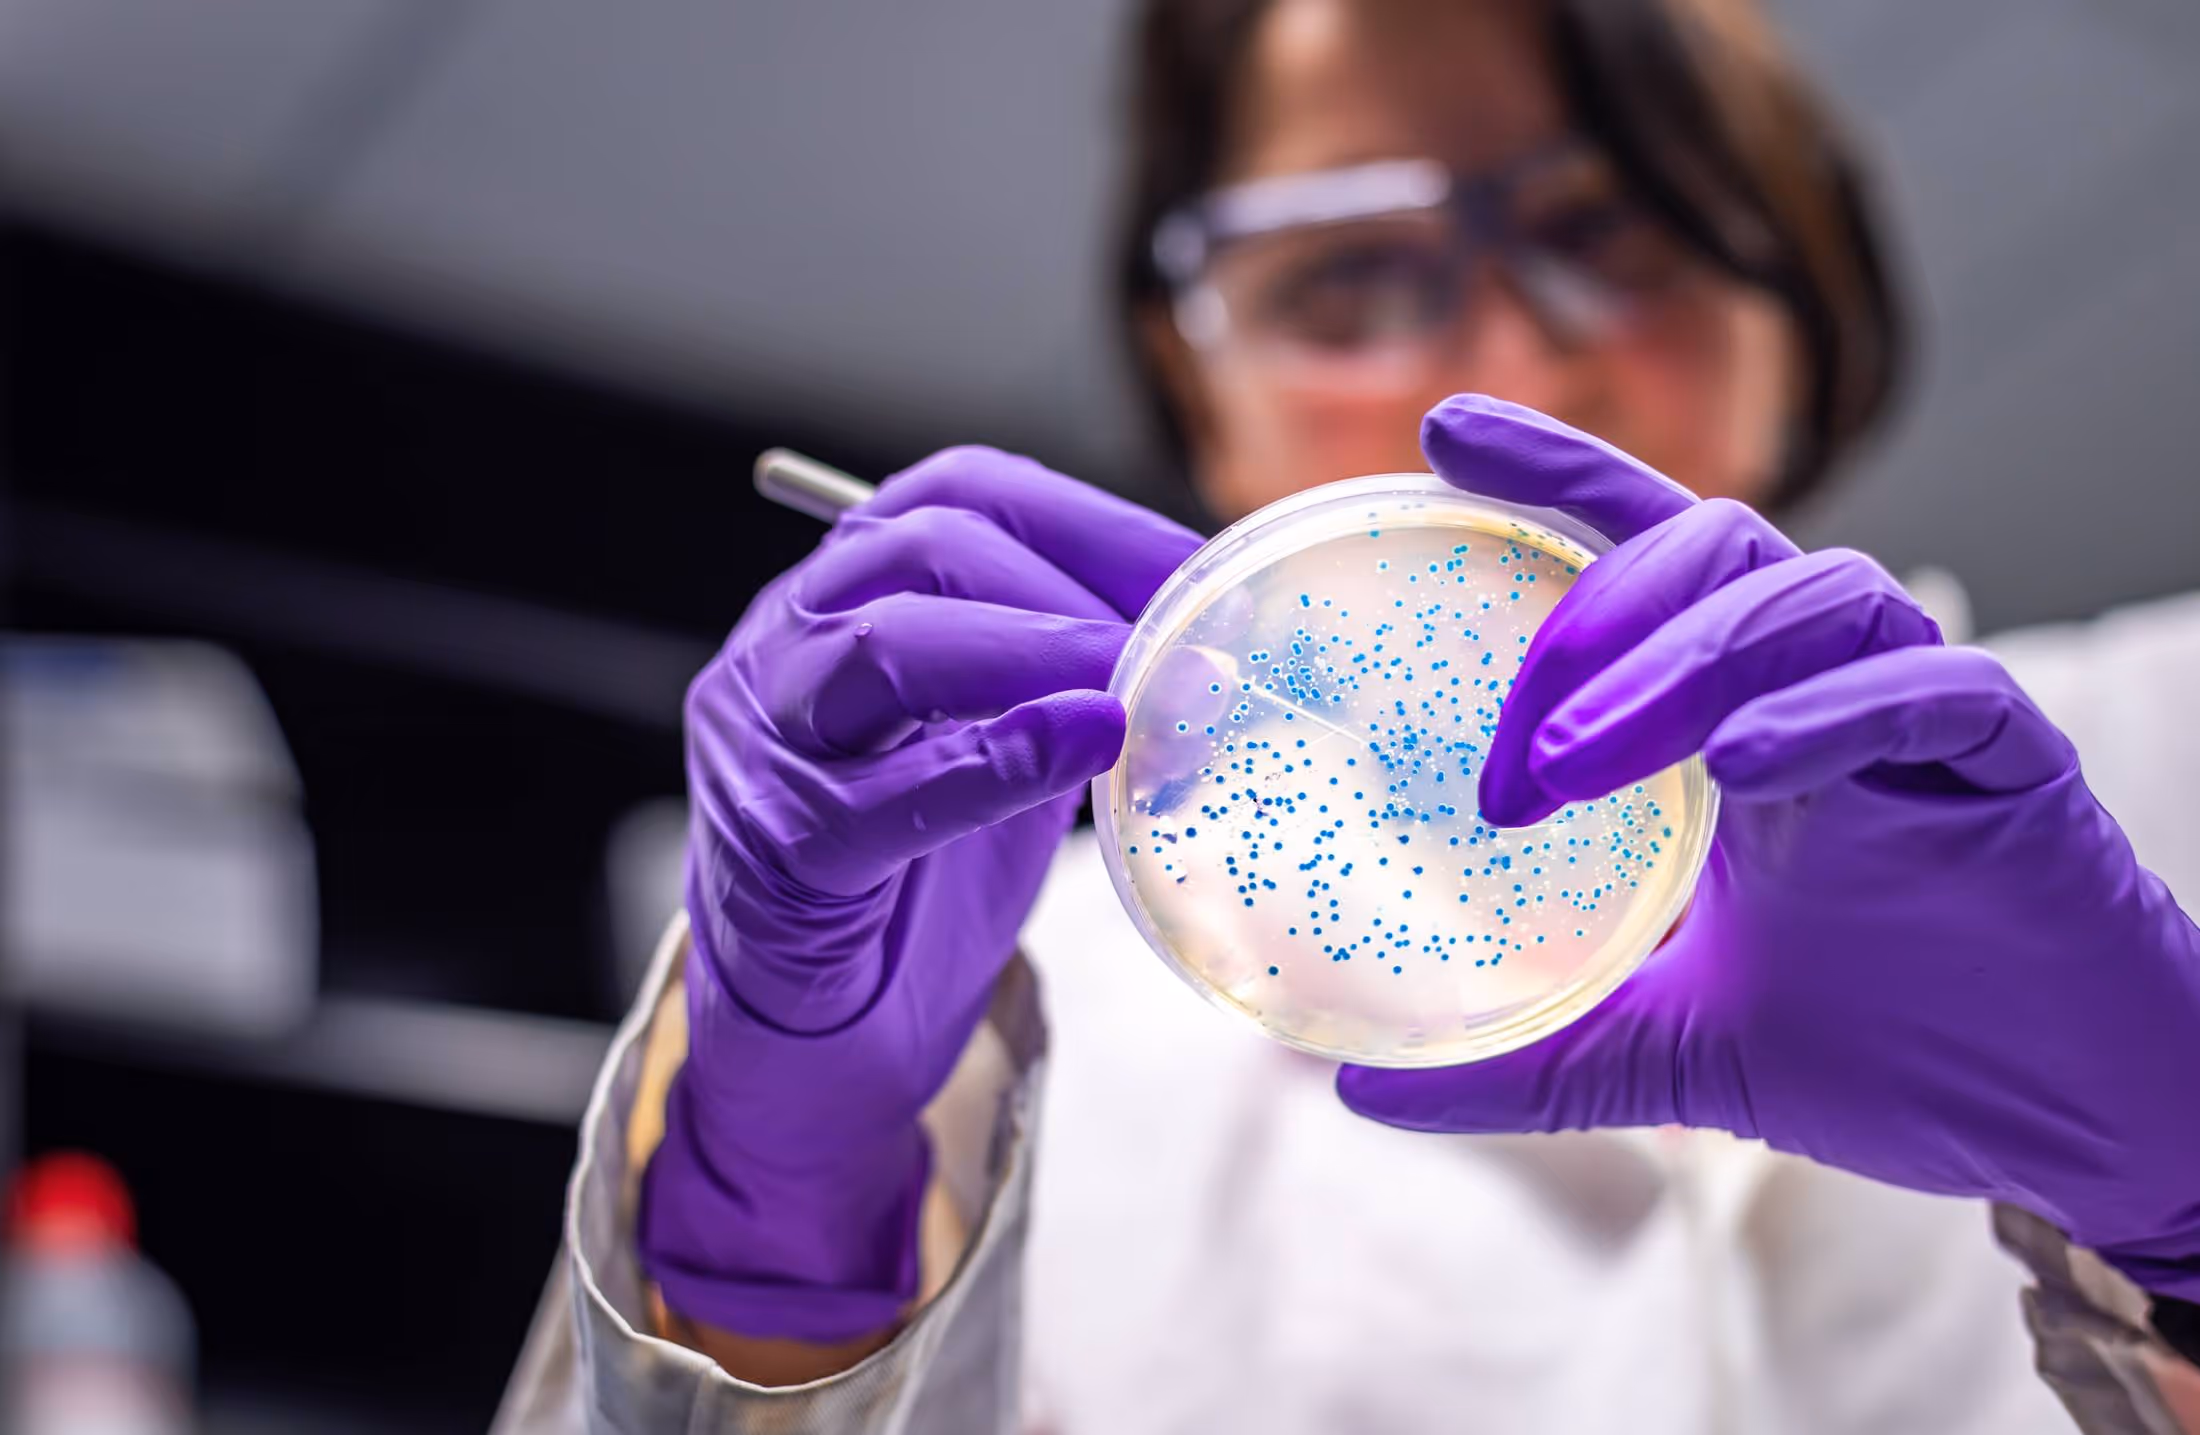
Superbactérias: o que são, como surgem e novos métodos para combatê-las

Já ouviu falar em superbactérias? Sabe como elas surgem e por que ameaçam a saúde global? Esses seres são resistentes a vários antibióticos e, com isso, podem colocar a vida em risco.
Na verdade, as superbactérias se tornam resistentes por causa de uma mutação, condição relacionada a alterações em seu DNA. Porém, um dos fatores que mais contribui na resistência bacteriana é o uso indiscriminado de antibióticos.
Então, se você está se preparando para o Enem e pretende ingressar na faculdade de Medicina, este tema é de suma importância. Confira, agora, o que são superbactérias, a sua relação com a resistência a antibióticos, além de conhecer as boas práticas que reduzem os seus impactos sobre a saúde. Boa leitura!
Afinal, o que são superbactérias?
Antes de explicar o conceito, convém destacar que as bactérias comuns são, em geral, muito sensíveis a vários antibióticos. Tais medicamentos são amplamente empregados no controle das infecções, por serem capazes de matar as células bacterianas e impedir a sua evolução.
Já as superbactérias são mais difíceis de controlar, pois elas são cepas que desenvolveram resistência a diferentes tipos de antibióticos. Isso dificulta o tratamento com o uso de antibióticos convencionais.
Geralmente, essa resistência pode surgir naturalmente devido à capacidade de adaptação ao ambiente. Todavia, isso é mais comum quando existe exposição repetida a antibióticos.
Assim, a resistência às superbactérias é uma preocupação que desafia a saúde pública. As razões são diversas: risco de infecções graves e potencialmente fatais, que podem, inclusive, desencadear um surto ou até mesmo uma pandemia.
Você sabe como são classificadas as cepas das superbactérias? Confira, agora:
- MRSA – Staphylococcus aureus resistente à meticilina;
- CRE – Enterobactérias resistentes a carbapenêmicos;
- VRSA – Staphylococcus aureus resistente à vancomicina.
Na rotina da Medicina, essa classificação é importante para direcionar a escolha de tratamentos alternativos, com base no perfil de resistência da bactéria. Por isso, nos cursos de especialização médica nessa área, o foco é a busca de estratégias de prevenção, com vistas ao melhor controle de infecções causadas por superbactérias.


Como surgem?
Em geral, as superbactérias surgem devido a um processo de seleção natural e adaptação aos ambientes. Como já descrito, o fator de influência é o uso inadequado de antibióticos, temática bastante abordada na rotina dos estudantes de Medicina, inclusive.
Em termos de saúde global, o surgimento de superbactérias é um problema bastante complexo. Ou seja, isso requer esforços coordenados das instituições responsáveis pelos serviços de saúde, tanto em níveis locais quanto global.
Para superar os desafios ligados à resistência aos antibióticos, é necessário a implantação de práticas adequadas de prescrição desses medicamentos. Igualmente relevante é a adoção de medidas estratégicas de controle de infecção bacteriana nos ambientes de saúde.
Geralmente, o surgimento das superbactérias está associado a:
- mutações: os microorganismos sofrem mutações genéticas aleatórias, levando à resistência aos antibióticos;
- uso inadequado de antibióticos: o uso irresponsável desses remédios eleva as oportunidades de desenvolver resistência bacteriana;
- ambientes de saúde: em hospitais e clínicas, as chances de selecionar bactérias resistentes é maior.
Quais os cuidados com o uso de antibióticos?
Um dos aspectos cruciais dessa temática é entender a relação entre o surgimento das superbactérias e o uso indiscriminado de antibióticos. Ter consciência disso é fundamental para prevenir a resistência bacteriana e, assim, garantir que esses medicamentos possam ser utilizados com eficácia no tratamento de infecções.
Sem dúvida, a terapia com antibióticos é, cada vez mais, uma ferramenta eficaz no controle de infecções bacterianas. Logo, é necessário promover educação preventiva no sentido de evitar o uso irresponsável desses remédios.
Para tanto, destacamos alguns cuidados importantes nesse contexto, que podem ser vistos nos subtópicos seguintes!
Use apenas quando necessário
Mesmo que seja clichê, ainda é preciso reforçar que os antibióticos são eficazes somente contra infecções bacterianas. Ou seja, não se pode utilizar tais fármacos para combater resfriados e gripes, por exemplo.
Siga as instruções do médico
Igualmente relevante é tomar a dose de antibióticos prescrita pelo médico. Também é necessário seguir as orientações quanto à quantidade, os intervalos corretos e o tempo determinado do tratamento.
Mesmo que os sintomas desapareçam antes de terminar o tratamento, a medicação não deve ser interrompida. A interrupção do uso antes do período previsto pode promover o desenvolvimento de superbactérias.
Não compartilhe
Os antibióticos são prescritos pelo médico com base na condição de saúde específica de cada caso. Ou seja, um antibiótico que serve para tratar uma pessoa, nem sempre será eficiente no tratamento de outra. Logo, é preciso compreender que a automedicação é sempre um risco à saúde.
Ainda que seja a mesma doença, o remédio pode não funcionar. Isso acontece devido às características individuais, tais como idade, peso corporal, história clínica e outros fatores que influenciam a ação dos fármacos no organismo. Portanto, somente o médico tem a competência de prescrever o antibiótico adequado a cada caso.
Adote medidas preventivas
Ações como a lavagem das mãos regularmente, os cuidados com a higiene pessoal e a redução do contato próximo com pessoas doentes são essenciais na prevenção de infecções bacterianas.
Por que as superbactérias ameaçam a saúde global?
Como já visto, as superbactérias são resistentes a múltiplas classes de antibióticos. Com isso, o risco de levar ao desenvolvimento de infecções persistentes, prolongadas e potencialmente fatais é bastante elevado.
Esse problema afeta a maioria dos pacientes que não respondem aos tratamentos convencionais, como aqueles que são imunossupressores, ou que têm doenças autoimunes. Tanto em ambientes locais ou globais, as superbactérias ameaçam o planeta, aumentando os riscos de morbidade e mortalidade, sobretudo nos hospitais.
Por isso, o impacto nos sistemas de saúde é imenso, já que a resistência bacteriana contribui para sobrecarregar o sistema pelo aumento da demanda. Essa condição é mais comum em pacientes com imunidade comprometida, tais como crianças, gestantes, idosos e pessoas com doenças crônicas de difícil controle.
A adoção de medidas urgentes na prevenção e controle do impacto das superbactérias é de suma importância
Nesse contexto, convém estimular a conscientização quanto ao impacto da automedicação e do uso indiscriminado de antibióticos sobre a saúde coletiva. Faça a sua parte e dissemine a informação!
Gostaria de receber mais conteúdos como este em seu e-mail? Assine a nossa newsletter!


Tags: